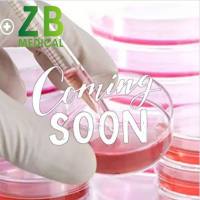
产品图

上海致备生物科技有限公司免费会员
公司介绍
上海致备生物科技有限公司,由中科院、上海交大,复旦大学等一批优秀的博士组成的博士技术团队;公司定位于为客户个性化定制解决具有一定技术难度的、公司技术团队自身擅长的技术服务及基础生物医学科研CRO服务;目前公司专注于2大优势实验方向,一方面是公司技术团队自身擅长的优势技术服务包括RNApulldown,RIP,CHIRP,Chip-seq,构建悬浮细胞稳转株,原代细胞永生化,耐药株,Western blot等;另一方面是常规的基础生物医学科研CRO服务,公司500多平实验室包括各种试剂盒检测平台,核酸水平的研究平台,蛋白水平的研究平台,细胞水平的研究平台,蛋白组学的实验平台,疾病动物模型的研究平台,整体实验设计服务平台等;
供应产品

DU145-LUC-BSD (人前列腺癌细胞-荧光素酶标记)
价格:¥4500
大鼠脂肪干细胞-RFP(大鼠脂肪干细胞-红色荧光蛋白标记)
价格:¥6000

143B-LUC(人骨肉瘤细胞-荧光素酶标记)
价格:¥4500

人脐静脉内皮原代细胞-GFP(人脐静脉内皮原代细胞-绿色荧光蛋白标记)
价格:¥9000

BXPC-3-LUC(人原位胰腺腺癌细胞-荧光素酶标记)
价格:¥4500

HEK293T-EGFP(人胚肾细胞-绿色荧光蛋白标记)
价格:¥4500

SMMC-7721-coGFP(人肝癌细胞-绿色荧光蛋白标记)
价格:¥4500

MV4-11-LUC-eGFP(人急性单核细胞白血病细胞-绿色荧光蛋白标记)
价格:¥4500

H22-LUC(小鼠肝癌细胞-荧光素酶标记)
价格:¥4500

HEPG2-COGFP-PURO(人肝癌细胞-绿色荧光蛋白标记)
价格:¥4500
详细信息
| 公司名称 | 上海致备生物科技有限公司 | 企业类型 | 民营 |
| 经营模式 | 企业地区 | 上海-嘉定区 | |
| 经营地址 | 嘉定区科福路368号B座2228室 | 主要产品 | 技术服务,检测分析,细胞系,原代细胞 |
| 公司成立时间 | 2017 | 公司网址 | http://www.biozb.com |
免责声明:以上所展示的信息由企业自行提供,内容的真实性、准确性和合法性由发布企业负责,丁香园对此不承担任何保证责任。


